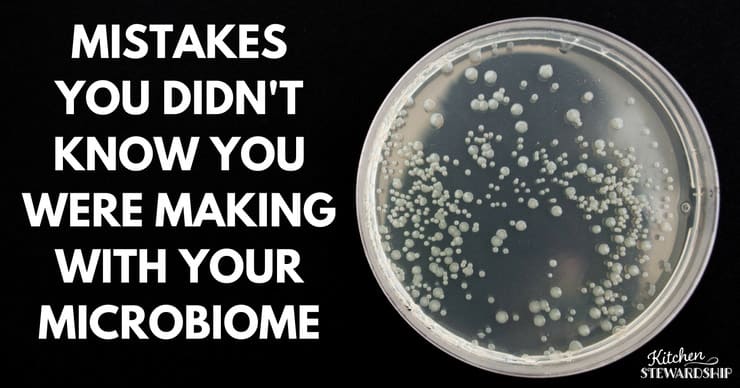
Mistakes You Didnt Know You Were Making With Your Microbiome 1 F

When Michael Pollan, Dr. Oz and two real life formerly-fat women schooled me on the relationship between gut bacteria, antibiotics and weight gain all in the same week, I knew I had to dig deeper into the issue.
The number of times I’ve heard the phrase “human microbiome” since then, particularly in relation to it being the next frontier of medical research, is more than considerable. (“Then” was back in February when I did this great interview, read Pollan’s Cooked, and caught a Dr. Oz article in the checkout line at Meijer in a magazine.)
If you haven’t already heard from both mainstream and real food/crunchy-culture media sources, the human body is host to over 3 trillion different bacteria, many of them beneficial to our health. Collectively, they’re termed the human microbiome, and now that gene sequence has been mapped, science is moving on to figuring out the who’s who of the little bugs in our systems.
Many scientists are nearly giddy with anticipation about the next discovery of bacterial importance in this process, fascinated, as am I, by what connections we may be able to pin between our bacteria and specific aspects of our health.
Although there’s plenty to read about the microbiome and we will likely be inundated with more for years to come, I hope to give you a nice foundation of basic information today, something you can refer to as you read about the microbiome in the years to come just to make sure you understand where these bacteria come from, a few examples of the importance they play in our health, how imbalances might occur and what we can do about it, at least with the knowledge we have at this moment.
You know what’s funny? My spellcheck doesn’t even recognize “microbiome” as a word yet. I predict that’s about to change…
This post is sponsored by Well Future, makers of the Well Belly probiotic for kids.
Nice to Meet You, Mr. Bacterium
Where does our microbiome come from?
It is widely accepted that newborns in the womb have no personal gut bacteria yet, that their existence is sterile. (Will this understanding change soon too? Possible! We’ll see…) Therefore as soon as the baby is exposed to the world, i.e. once the membranes have broken or are torn by human intervention, resident bacteria begin the process of settling in.
Your very first experiences on earth outside your mother, therefore, turn out to be critical in populating your own microbiome, the little guys who will be with you, generally, unless disrupted, for your lifetime.
Vaginal births impart the mother’s bacterial composition, more or less. The birth canal begins to populate with different bacteria than usual as the mother’s body prepares for childbirth, which is such a phenomenal demonstration of God’s design for our microbiome, it blows me away. Many of the bacteria present awaiting baby are lactobacilli, who function in part to help humans digest milk, for example – including breastmilk. Perfect design…
If the mother’s bacterial or fungal balance is off, however, such as a mother with candida or her own poor gut bacteria, that will be passed to the child in some way.
Caesarean sections are a much different story – newborn infants are covered with the bacteria of other people’s skin first, not necessarily even the mother’s, in spite of sterile hospital procedures. Their microbiome beginnings are far less diverse, and most likely far less appropriate and healthy, than vaginal birth babies.
I predict that as we learn more about our early flora, C-section babies will be inoculated somehow with bacteria, etc. from their mother’s vaginal tract – or at least somehow given a set of bacteria that scientists think is optimal, probably starting out very regimented and eventually coming around to realizing that God knew best and just using the mother’s own composition of microbiotics.
There’s Some Interference on the Line
As important as a human’s first experience with the world of bacteria and fungi is, there are a multitude of ways in which our day-to-day activity can improve or disparage our own microbiome. For example, every time we eat, we are potentially affecting the colonization of our gut, either by adding beneficial bacteria directly, feeding the bad guys, or even feeding the good guys.
In the American culture, we tend to feed the bad guys or simply kill everybody in there more often than we do beneficial things, which is likely manifesting itself in the upsurge of irritable bowel syndrome, auto-immune disease, and even obesity.
Germ Warfare and Accidental Casualties

One of the major mistakes of our modern era is the overuse of antibiotics and antibacterial cleaning agents and the lack of understanding about how to heal the gut after a required antibiotic. (See my thoughts on the dangers of antibacterial soap, for example, and an exploration of the pros and cons of hand sanitizers.)
I read something a few years back that described antibiotics as a “hand grenade” that obliterates all bacteria in its path, both good and bad. This can totally destroy even a healthy microbiome instituted via a natural birth, and if the newly upturned (and rather empty) soil of your system isn’t repopulated with healthy bacteria first, it’s most likely that the diet and environment typical to most human beings in industrialized societies will quickly populate the gut with “bad guys.”
I wrote more on the subject of what to do after antibiotics here, but I want you to think about how many newborns get antibiotics while they’re still in the hospital (or even during delivery), how many children under two get antibiotics for ear infections, fevers, and the like, many of which probably aren’t even necessary, and how many rounds of antibiotics you’ve had in your life.
Did you ever think you had to take steps afterward to fix the damage done by the medicine that was supposed to fix you?
Many of you savvy KSers surely have, but likely not throughout your entire life. Any of those antibiotics could have upset your microbiome enough that you have trouble losing weight, that you’ve been diagnosed with IBS or other bowel diseases, or that you may have a food sensitivity. The balance of your gut is so important – no hand grenades allowed!
Our Best Weapons in the Micro-Battle

Unfortunately, most folks don’t even realize they’re in a battle for the health of their own microbiome, and they certainly don’t know the weapons they need to employ to come out victorious.
If you’ve had antibiotics, if you’ve grown up on processed, sugary foods, if you know you suffer from candida or IBS, what can you DO about it?
Starvation
The first step is to starve the bad guys, in my opinion (but you should really do all three parts here).
Processed foods, refined flours and sugars are culprits in the “fat bacteria” studies and also have been shown to increase the percentage of unhealthy bacteria in one’s gut simply by creating an inhospitable environment in which they thrive.
So if you think your bacteria might not be very well balanced, cut out foods like:
- white flour
- sugary sweets
- soda and other liquid sugars!!
Good Guy Army
Step two is to make sure you have plenty of “good guys” to edge out the bad guys. Good guy bacteria are called probiotics, and they assist in many aspects of digestion, immunity, and even metabolism. (Who knew you had such a team on your side?!)
If your bacterial balance has been thrown off by a lifetime of processed foods, a few rounds of antibiotics or even as far back as a C-section birth, you need to help the probiotics find their way back to your gut so you can shift the balance back toward “helpful.”
You can obtain beneficial probiotics through food:
- Yogurt (okay), kefir (even better!)
- Homemade yogurt is easy to make, and homemade dairy kefir or water kefir is even easier. Note: often kefir in stores is highly sweetened, so be sure to read the label and look for PLAIN kefir if you purchase instead of making it yourself.
- Sauerkraut (but only traditionally fermented, not the pasteurized stuff you buy in most grocery stores)
- Homemade kimchi, which I prefer over sauerkraut
- Other fermented vegetables or cultured dairy
Or via supplements (or both, best case scenario).
The generous sponsor of this post is Well Future, creator of a special probiotic specifically formulated for infants and children called Well Belly. Well Belly has 8 strains of probiotics, each with research backing its beneficial nature for children.
Sponsoring this post meant that I actually did the research and got it written
instead of just thinking a lot about it (did you notice I’d been pondering the topic for over 6 months?), so I’m grateful to Well Belly for the nudge! I think everyone should understand more about their microbiome and how to keep their gut bacteria balance, happy and healthy.
Many of you are going to ask why we’re working with Well Belly when I’ve already mentioned many times that my family takes another brand of probiotics regularly, so here are a few reasons you might want to look into Well Belly:
- It totally disappears into yogurt or applesauce, no taste, no color (I’m sure it would into juice, too). This is important for kids who won’t take something special off a spoon and much different from the green, icky-tasting probiotic powder my husband and I use.
- My kids are huge fans – when they even know that I’ve put it in their yogurt. It’s truly undetectable, unless you’re in a hurry and don’t stir well, after which you’ll hear: “Mom, what is this blob of sticky stuff in my yogurt???” I learned!
- It’s especially formulated for very young children.
- The cost is about 50 cents per day, comparable to or better than many probiotics out there.
- It’s very easy to serve – the scoop is included and the serving is one scoop per day.
If your kids have had antibiotics or were born via C-section, or if anyone in your family has signs of digestive distress, I’d highly recommend a probiotic supplement, even if you’re eating yogurt every day. Food sources are great and might be sufficient, but if your balance is really off, it’s likely that you’ll need powerhouse help at levels beyond a scoop of sauerkraut (but food is awesome for maintenance if you feel you’re in a good place!).
In fact, if you’re a human being – I’d recommend a probiotic supplement.
Remember this is just one mom gabbing to another, not a doctor, nurse, or anyone who knows much of anything other than great results in my own family and via testimonials from readers.
For All Ages…
Some Quality Probiotics
Some of these I’ve used, some I’m planning to use, and some have been recommended by friends and professionals alike. It’s good to remember a few things about probiotics: 1. People should get different colonies of probiotics, so switching brands/strains every so often (6 weeks?) is good practice. 2. What works great for one person’s needs doesn’t always work for another.
I’ve personally tried:
- Just Thrive Probiotics – this one can be taken during antibiotics and not be rendered ineffective, which almost all other probiotics are! It’s the top-recommended probiotic overall by Nutrivore Dr. Sarah Ballantyne. 😮 (Be sure to use the code Katie15 for 15% off; also found on Amazon and from Perfect Supplements where you can use the coupon KS10 for 10% off!)
- Seed Daily Synbiotic – the new player in the field but recommended by superstars like Chris Kresser for its unique probiotic/prebiotic synergy. Here’s my full review including a number of surprises for my thinking and a 15% off code!
- Note: If you’re struggling with digestion, especially constipation, or you feel like you really need to populate your gut with healthy probiotics, I would recommend Saccharomyces Boulardii in addition to any other you choose (except any above which include this strain). Saccharomyces Boulardii is research-proven to get through the digestive tract without being killed, which is rare.
- Balance One probiotics with a unique time-release formula
For Little Ones:
- Mary Ruth’s liquid probiotic is a liquid probiotic that doesn’t need to be refrigerated and tastes like…nothing! It’s my new favorite for administering to kids!
- Balance One Kids probiotics are sugar-free, easy to swallow, and made in the USA.
- Raise Them Well is a brand I trust, and they have a great chewable probiotic for kids. Hyperbiotics also has a chewable probiotics for kids that we’ve used!
- Just Thrive now has a gummy probiotic for kids (and gummy-loving adults)! Kimball-kids approved! Be sure to use the code Katie15 for 15% off.
- Llama Naturals also has a gummi pre- and probiotic, and we love them!
Recommended by experts I trust:
- Biokult – highly recommended by many, including the GAPS diet
- Klaire Labs Pro-biotic complex V-caps or Ther-Biotic Complete (25 billion CFU)
- Probiophage DF (7 dairy-free strains)
- Transformation Enzymes (5 billion CFUs that may get through digestive tract…)
- Primal Blueprint (4 strains, 10 billion CFUs) Use code KS10 for 10% off!
- Pro-Bio from Enzymedica (8 strains)
- Syntol from Arthur Andrew Medical (13.6 billion CFUs with prebiotic, spore germinating blend, yeast cleanse)
- Smidge (8 strains, formulated for sensitive digestive systems, allergen-free, also have an infant probiotic powder)
MREs for the Good Guys

Once the good guy army is in place, you’ve got to make sure your own gut is an hospitable environment for them. They’ll get out of dodge if they don’t have anything to eat, just like teenage boys and any other organism!
So what do probiotics eat?
Answer: The new buzz word in media-driven medicine and pop health culture: prebiotics.
Luckily, just because pop culture is hyping it doesn’t always mean it’s wrong. It might mean that you’ll have to wade through some marketing to find the “real food” versions of prebiotics and sift out the still-processed or too-new-to-be-traditional stuff.
Prebiotics basically means fiber that is indigestible for humans but feeds the bacteria awaiting its passage into the gut. Along with probiotics, they’re found in human breastmilk, which is a key factor in proving in my mind that humans were designed to require them.
The big-word terms that we need to consume include soluble fiber, inulin, oligofructose, possibly pectin, fructooligosaccharides (FOS), galactooligosaccharides (GOS), and other oligosaccharides.
In food terms, that translates into certain foods like bananas (not overripe), honey, raw garlic and raw onions that actually help feed the good bacteria, making them healthy and robust and fostering growth, and thus greater health for the human host. Other prebiotic foods include leeks, Jerusalem artichokes, asparagus, jicama, chicory root, dandelion greens, kale, radicchio and other leafy greens, apples, pears, figs and prunes – mostly only when they are eaten raw. It is also found in whole grains, but lesser so – best to stick to veggie sources whenever possible. (See a top 10 list including amounts in each source here.)
The tricky part of pop culture medicine is that when something is proven to be helpful, it seems food processing companies will try as quickly as they can to come out with products that meet the need and can’t really be grown in the ground or created in a home kitchen, thereby encouraging couch-residing Dr. Oz fans to buy their products.
I think “resistant starch” and sugar substitutes with inulin like stevia blends fall into that category – the Dr. Oz article in First for Women magazine quotes: “Fostering skinny bacteria doesn’t mean you have to give up treats…you can turn desserts into diet superfoods.” The article recommends making chocolate cupcakes with resistant starch flour (3 lbs. for $10) and stevia. I’ve been meaning to look into the science behind resistant starch – which also includes eating green bananas and undercooking pasta – for a long time.
The bottom line is to eat some fiber and raw veggies in your diet and know that you’re giving your beneficial bacteria a good meal so they can keep doing the job of keeping you healthy from the inside out.
But Mommmmm, Do I Have To?
Is all this “care and feeding” of our tiniest residents really that important? Do we need to bother?
As I mentioned, we’re just beginning to scratch the surface of how our resident bacteria impact our health, but here are only a few examples of what we’re discovering so far:

1. Your Microbiome is Making You Fat
That’s right – fat.
Just this year a study came out demonstrating that one’s resident bacteria can actually have a major impact on weight gain, regardless of current diet. Scientists took bacteria from twins, one overweight and the other trim, and shared them with mice. The mice, even on the same diet, matched their human counterparts exactly – fat bacteria made them fat, skinny bacteria kept them thin.
Other researchers followed up with some studies on how to switch “fat” bacteria with “skinny” bacteria, and it looks like the answer is to get good probiotics into the system via food or supplements and then feed them with fiber, aka “prebiotics” (see above for a list of examples). Processed foods were a big problem and cause of the “fat” bacteria taking over, FYI.
I even read about the link between gut bacteria and insulin resistance in the book Why We Get Fat (and what to do about it) – more and more information will be coming out every month, I’m sure.
2. The Microbiome and Genetically Modified Foods
Another example of “what we didn’t used to know” that now has an impact on our health – I was listening to some talks on genetically modified foods recently, and the speakers said that since glyphosate, the main ingredient in Roundup, cannot act on humans in the same way it does on plants, its creators “proved” that it can’t hurt us.
The background: glyphosate blocks an enzyme pathway that is in plants, but not humans. By interfering with the enzyme, glyphosate (Roundup) makes the plants unable to synthesize these amino acids (proteins): phenylalanine, tyrosine and tryptophan, at least some of which are part of human biology and survival.
But since humans can’t have their “shikimate” enzymes blocked, because we don’t even have any, glyphosate couldn’t possible interfere with our own aminos or overall health.
That’s what the company who makes Roundup would like you to believe.
It turns out that many of our own gut bacteria do have shikimate enzymes, the lucky bums, which means they are affected each time we consume any glyphosate, such as non-organic products that are made from corn or corn syrup.
So the “non-toxic” glyphosate is messing with gut bacteria in a serious way, which of course impacts our health in a serious way, even though the herbicide doesn’t actually hurt us. It’s all connected…
3. Oops, My Gut is Leaking All Over the Place
Finally, my last example (but far from the end) is what naturopaths have understood for a long time but that rarely seems to hit the mainstream, probably because pharmaceutical companies couldn’t figure out how to make money from the news. It’s the connection between the gut wall, probiotics, and food sensitivities.
We’ve discussed a lot about this issue on KS before, most prominently in an awesome guest post on irregularity and stomach pain after eating by Lydia Shatney, certified nutritional therapist.
But basically, if you don’t want to click over to read that article (although you should!), the lining of the intestine becomes too porous as a result of certain drugs (birth control may be one), food sensitivities, alcohol and more. When food proteins “leak” through the wall of the gut, it causes not only intestinal distress, but also further food sensitivities and bacterial imbalances. It’s a vicious cycle, and our gut bacteria are at the hub.
Sources: 1, 2 (Link no longer available), 3, 4, 5, 6, 7, 8, 9 (Link no longer available), 10 “Heal Your Gut to Melt Away Your Belly,” First for Women magazine, 3/10/14
Your Microbiome: Feed it Well
If you’ve made it this far down in the post, congratulations. I hope you are convinced not only that your resident bacteria are important to your health, but that you need to do what you can to take care of the good guys and balance out your system.
I, for one, am super excited to see what science learns over the next decade as they map our bacteria’s genes and connect them to certain body systems and ailments. I think it will open up a whole new world of treatments and preventions for disease, and it definitely lends itself to whole foods and natural remedies. Keep your eyes peeled for more!
Was this helpful to you? Why not pin it and share with friends?
Disclosure: This post was a paid post from Well Future, but the research, opinions and possible mistakes are all my own. There are affiliate links in this post from which I will earn some commission if you make a purchase. See my full disclosure statement here.




Thanks for all this great research, Katie! I am particularly interested in this part, which was news to me:
By interfering with the enzyme, glyphosate (Roundup) makes the plants unable to synthesize these amino acids (proteins): phenylalanine, tyrosine and tryptophan, at least some of which are part of human biology and survival.
Tryptophan is used by the body to make serotonin (a neurotransmitter, carries messages around the brain) and melatonin (a neurohormone that helps with sleep).
Since the GMO crops came into our food supply, we’ve seen an increase in depression and other disorders that are treated with selective serotonin reuptake inhibitors (drugs like Prozac that keep serotonin in the synapses so you can feel its effect longer, which can compensate for deficiency of serotonin in the body) and in the use of prescription sleeping pills. Just a coincidence??
You have finally given me a reason I can buy for NOT buying GMO corn!
They are two and four and neither has had any.
My poor husband, though …. he spent his childhood on course after course of them, and more in adulthood. Every time he goes on them, his health declines. I am convinced they triggered his gluten intolerance.
I used to be on them at least once a month. Now I do foods like raw honey, juices, garlic, ferments like kraut and kefir, and learning about essential oils.
4 kids total. 2 4, 6, 8 so that total would be 1. Total. Yes. God has blessed me with the info. On how treat naturally 🙂
I’d have to go back to my medical files to be sure, but I believe both of my kids (oldest is 12) have had no more than two rounds of antibiotics each. For each child, one dose was begun at emergency room visits, and both were very possibly unnecessary or at least, preventable. (sigh) So I felt compelled to continue them. But both have also been prescribed antibiotics they refused to take. We did a “wait and see”, and both an ear infection and a case of folliculitis cleared up on their own.
Interesting post- I’m excited to see what new research will be done in the years to come.
Something I was wondering about was the affect that worming tablets might have on our gut systems. My family recently treated ourselves using the standard worming tablets and it got me thinking- does this medicine obliterate ALL organisms in it’s path?
Would love to hear from anyone who has information on this topic.
Emily,
I wish I knew something that would help you, but I don’t know how worming tablets work. I’m fairly certain that probiotics are recommended after a parasite cleanse, so it’s something you might look into via some Internet searching etc. Good luck! 🙂 Katie
Help! I was Group Beta Strep (GBS) positive with my two previous pregnancies. I received IV penicillin during labor with my first and had a horrible reaction (burning in my arms). It wasn’t a normal birth and my dd ended up in the NICU with an unknown infection for a week. With my second I delivered at a birth center with a midwife and used Hibiclens during labor (my ds was born in the caul anyway so he was protected in that sense). I am currently 36 weeks pregnant with #3 and will be having the GBS swab on Monday, ugh. I feel I am almost more worried about the results from this than I am the birth! Due to finances, we have chosen to go back to the hospital for birth (hubby isn’t keen on a home birth but I am NOT thrilled about going back to the hospital but we will be using the same midwife as my doula, thankfully). I douched once the other day with a generic Hibiclens (same active ingredient) and plan to again. I’ve read Wellness Mama’s tips (doing the extra vit. C, probiotics, etc.) and even the Evidence Based Birth website regarding GBS. So, my question is this: What would you do in my situation if you got a positive result? I’ve been told I can do another IV antibiotic that hopefully won’t have the same side affect as before but I am going for a non-medicated birth with very low intervention if possible. I do not wish to take antibiotics during labor. I may not even get there in time to have them administered if I progress quickly but being at the hospital longer opens the door to more intervention. Thankfully I have a good OB who thinks a lot of intervention is unnecessary. I am just sick about the whole thing. But a healthy baby is paramount. I don’t know what’s best. Please help!
I had c-sections with my last 3 kiddos and so had antiobiotics. I just used the probiotics that my pediatrician recommended for my newborns for a few weeks post-birth. They’ve never had any problems as babies or kids now with tummy troubles or anything like that.
GBS+ can be an issue (I know of 2 babies who’ve died because mom did not get antiobiotics) and the risk to benefit ratio (risk of death vs. benefit of baby not getting antiobiotics through mama) is a no brainer for me at least. And if you use all that stuff you are doing before the test and it’s negative, you should do it after and leading upto the birth too. It would really suck to be negative because of it then positive at birth and not know it.
Good luck to you! For my babies, the probiotics worked like a charm.
rcb,
I’m glad you had a good experience with the probiotics, and impressed that your ped was wise enough to recommend them! It’s great that your kids have good digestion now, and as much as I hate to be a pessimist, I do think it’s important to note that issues could crop up later and also that there could be underlying gut or microbiome imbalances that you can’t determine from external symptoms. You just never know what antibiotics do (see Sheila’s note on this post too). So probiotics after abx are good, but likely avoiding abx is best, still, in my opinion. 🙂 Katie
Well, with c-sections it’s protocol and one that I’m okay with. And I would much rather have my last 3 kids have microbiome issues later in life than the life-long birth injury my non-antiobiotic’d, homebirthed, firstborn son has. Microbiome seems to have nothing on shoulder/back/arm deformities and limited use of an arm…
This article goes to show, you can still make the best choice for your family and there is always going to be a con. haha. Gotta love nature!
Oy yi yi, I’m so sorry you had a birth injury, how awful! 🙁 🙁 🙁 Yes, you definitely made the best choice, and that you had probiotics right afterward is a great thing! 🙂 Katie
Mareth,
Some of those decisions surrounding birthing our kiddos and whether to follow the mainstream with vaccinations and such are my least favorite parts of parenting (said by someone who carried a fit-throwing 3yo out of church just this morning, a close second least fav…). 🙁 There’s no easy answer.
Of course please remember I’m not a medical professional in any way, just a random mom. I can really only tell you what I’ve done in the past. I was GBS positive for all 3 kids so far, and I chose no abx for the latter two. I wasn’t in the hospital long enough for either to have it anyway, and after a heart-to-heart with our pediatrician during which time she agreed that statistically, the rate of transmission is so low, and as long as we knew the symptoms to look for and gave abx if any of them showed up (fever, lethargy, etc.) we really should be fine with not giving our newborn shots of abx (my first had both IV during labor AND a shot after birth…ugh). After reading what Sheila says on this thread, and I know she does her research well too, I’m even more hesitant about abx for anyone unless known to be 100% necessary.
Soooo…I know what I would do. As for what’s best, it’s a risk either way. Sigh…
” I am just sick about the whole thing. But a healthy baby is paramount. ” ==> I agree wholeheartedly with this part!!
We have a certified nurse midwife this go-round, and she said if I’m GBS positive, she’ll share a lot of info on symptoms to watch for, including late onset symptoms which can happen a week after birth – something no one ever told me about before as they discharged us all from the hospital after the two-day period of watchfulness!!!!!
God bless your last few weeks of pregnancy, and may you have peace about whatever decision you make — 🙂 Katie
I was negative the first two times and chose not to get tested the third time around. It’s a tough call. I do know one baby who lost most of her large intestine to a GBS infection — but her mother HAD had the antibiotics! Also, some mothers who test negative for GBS have other bacteria that cause infections — and the doctors are lulled into complacency by that negative test and don’t discover the infection (e. coli or whatever) until later than they should. I’ve read statistics of GBS infections with and without antibiotics in labor, compared with other infections, and I felt that I would choose no abx either way. But I”m not you and each person does have to determine the risks they are comfortable with.
With a c-section, you can’t transfer your vaginal bacteria to the baby anyway, so abx don’t make the situation much worse. However, c-sections have been correlated with many other problems, and not getting mom’s vaginal flora seems to be the cause. A few doctors are actually swabbing baby’s mouth with a swab from mom’s vagina …. can you imagine? But if it works, I suppose it will become standard practice and prevent a lot of health problems later in life.
The birth went great! I chose to not get tested for GBS and opted out of any IV antibiotics. My insurance doesn’t cover the test and I knew I didn’t want antibiotics so I chose to not get tested. I know I took a risk and I am a bit curious if I was positive or not. I am thankful it went well and my dd is healthy! I am glad she got good bacteria from me at birth!
I found this quite interesting about the microbiome and birth, and thought I’d share:
http://www.oneworldbirth.net/microbirth/
Hi Katie. I would love to write a guest post providing much more insight into the microbiome and health connection as well as practical tips to optimize such. Please check out https://www.facebook.com/BiomeOnboardAwareness
Also… totally love the connection to Carl Zimmer’s article on bombing the biome (realize though that such is due to much in addition to antibiotics) as reduced biome diversity affects 40% of us. Biome manipulation truly resolves or manages all sorts of ailments and chronic disease/autoimmunity and is EASY to implement once the practical how-to is learned.
This is one of my Major Geek Topics …. so watch out for a long comment! 😉
First, I REALLY urge you to read Missing Microbes if you are at all curious about this issue. What I like about it is that it’s pretty mainstream and talks ONLY about the stuff that’s actually been proven. That means, of course, that it’s full of mystery and doesn’t really talk about leaky gut … however, what it DOES say goes to show that this microbiome stuff isn’t just an “alternative health” issue anymore. It’s proven, for instance, that there is a connection between celiac disease and antibiotics, as well as stuff like type 1 diabetes, asthma, and allergies. We might not be 100% sure of the mechanism, but we can see the correlation in thousands and thousands of people.
The bad news is, what isn’t substantiated at all is the idea that we can cure any of this. There’s really been no studies on curing bad gut flora, and though there are alternative providers trying different protocols, there’s no end to the different stuff they’re trying and we don’t know if any of them is working, or why. And the sad reality is that some of the bacteria that your gut ought to have can’t be obtained *anywhere* else. So even if you do some repair of the common lactobacilli, you won’t ever get back (so far as we know) any of the strains you’ve lost.
And that’s without asking the question, what’s in probiotics? They have some useful strains, but do they have the strains you’re missing? And can they get past your acidic stomach in order to reach your gut at all? Different brands have different claims — that their bacteria comes from dairy, from soil, whatever — but the fact is, only bacteria that is purified from human feces would be the stuff that your body is actually missing, because they live nowhere but inside humans. And even if you’re okay with consuming that, there’s still no guarantee they got the right strains because we currently have no idea whatsoever which strains of bacteria are connected to health and which cause harm. The level of scientific knowledge we’re at here is incredibly primitive and mostly composed of guesses … though in a generation we might know some helpful things!
If you have some useful bacteria alive, you can nourish them with lots of fiber. If the ones you need are extinct in your gut, you may be out of luck. They’ve had some luck with fecal transplants, but …. well, a lot of us struggle with the concept. Really, your best bet is to try to preserve the gut flora you have, because there’s no guarantee you can fix it if it gets messed up. So stay away from antibiotics as best you can. And if you do take an antibiotic, the author of the book recommends amoxicillin — it seems to have a smaller effect on gut flora than, say, z-pack or cipro. He hopes in the future we’ll have much more targeted antibiotics so we can knock out JUST the germ that’s harming us and leave the rest — but we’re not there yet, and the way the pharmaceutical industry works, there’s not a lot of money in developing those drugs. The companies might not even recover their investment, because they would be incredibly expensive to develop.
Sorry to be such a Debbie Downer here, and certainly probiotics won’t hurt you. And who knows, they *might* help to some extent. I certainly am a big eater of fermented foods, because they are traditional and tasty. But actually curing your gut flora is, unfortunately, not something we can do with any certainty. Maybe next generation.
I follow the microbiome science and liaison with various researchers which include clinical trials that are show dietary success with various diseases such as IBD, MS and Alzheimer’s… The most recent clinical trial just now getting under way (this I learned of at Little Rock, Arkansas’ 1rst International Microbiome and Health with a Focus on Autism conference) is now actively seeking autism patients for a SCD trial.
I am noting just a few of the studies evaluating dietary protocols for disease which can be linked to on my site at: https://www.facebook.com/BiomeOnboardAwareness for more specifics. Additionally, the play back of presentations for the conference I noted above just posted at my site for those interested. Enjoy the state of the art cutting edge researchers sharing wonderful science!
Sheila,
Aw, man! That is really bad news…I liked it better when there was an answer or two for “how can we fix this?” for those who have already had antibiotics. Everything you say does make sense, and I suppose the bottom line is to avoid abx at all costs (2 of 3 kids = success so far!!!!) and hope that probiotics do some helping at least with certain strains of probiotics, and maybe their presence will beat back some bad guys, etc.
It’s always amazing how much we DON’T know about our health, isn’t it? Now I’m even more anxious to find out what we learn in the next decade or two on this subject!!!
🙂 Katie
And of course then there’s the very next comment saying the opposite…typical! 🙂 I’m still hoping there’s something we can do… 🙂
I hope so too! What we really need are more randomized trials of the different gut-health protocols (SCD, GAPS, etc.) and also of different probiotics. Probiotics do seem to help with certain things, even if they aren’t a cure-all. I was interested to discover, though, that there are many times more organisms in probiotic foods than there are in capsules …. though taking both is probably the best bet, because the strains will be different. Diversity is always the best. We want a gut like the Amazon jungle, not like a zoo with three or four species to look at.
I really enjoyed this post and it has given me something to think about. My children were born via c-section and have struggled with constipation issues. I have seen that a probiotic and fiber has helped a lot, but we also still need to use a little Miralax. I have recently been told I have splenic flexure syndrome (basically a pain under my left ribs that I actually thought was a hernia from having quads). The pain was so bad, but it vanishes when I am on a regular dose of probiotics.
I do have a question though — I have found that only Culturelle (of the 3 I’ve tried) doesn’t make me have diarrhea. Even Culturelle does for a few days if I haven’t been taking it, and I noticed I also have to dump it out of the capsule (so maybe something in the capsule material is part of the issue?). I may try this Welly Belly stuff on me first, then the kids.
Last, as much as I liked this article, I wasn’t a fan of this sentence:
“Finally, my last example (but far from the end) is what naturopaths have understood for a long time but that rarely seems to hit the mainstream, probably because pharmaceutical companies couldn’t figure out how to make money from the news.”
I really dislike the ragging on pharmaceutical companies when there are actually a lot of people there trying to do a lot of good, as I know from working in the science field and knowing a lot of people in the field. I think this was a bit of casual negative bias that is a bit unfair when I expect you to be a reasonable source of information.
Other than that, thanks for this post!
Sonja,
Thanks for sharing your story, for expecting me to be a reasonable source of information, and for your gentle disagreement. I respect that completely!
I’m so glad you’ve seen such commitment to helping in the science field. That’s good to hear, since from the outside, especially with certain situations, it does seem that the bottom line is the only driving factor.
As for the probiotic/diarrhea reaction, it certainly seems like your body is trying to tell you something. A lot of folks describe “die off” when you’re talking bacteria, and I don’t have enough medical knowledge to know if that’s a possibility with your situation, but it might be something to look into to see if others who experienced the same thing figured out its origin. I find personally that there’s nothing like grains, especially refined grains, to constipate. A lot of people find regularity in a grain-free diet in just a few days.
I’d love to hear how Well Belly treats you and the kiddos if you end up trying it! 🙂 Katie
I am glad I finally read something that links birth control to stomach problems. I gained a lot of weight the only year I was on it. I basically felt like I had morning sickness the entire time. I also developed digestive problems, ending with a colonoscopy at age 22, and a diagnosis that I have too many mast cells in my colon, which require a daily dose of Zantac to block so that I don’t have diarrhea every time I eat. I knew it must be somehow connected to the birth control I was taking, but my OB seemed to think I was crazy when I tell him that is one of the reasons why I will never ever take it again. I have never read anything that links the two, but I always thought it was too big of a coincidence to be a coincidence. Now, 6 years later, I am still having trouble losing the last half of the weight that I gained from it.
Stacy,
A ton of women find that birth control has just that effect, so you are DEFINITELY not alone. I wrote a post on all the crazy side effects of the Pill long ago but unfortunately it is offline now because it was at another blog. 🙁 But if you start Googling, you’ll find plenty of research to back up your suspicions…no coincidence. Wouldn’t it be cool if some good probiotics helped you nail that last half?? Best to you, Katie